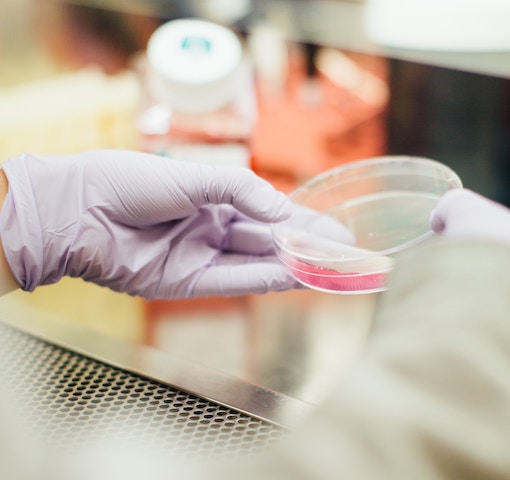

Reporting on technologies disrupting the healthcare industry. Mapping the trends in healthcare innovation and exploring novel technology solutions for the clinic.
Fundamentally supporting dialogue between the industries. Providing pre-seed VC investment advice and investigative journalism in emerging technologies.